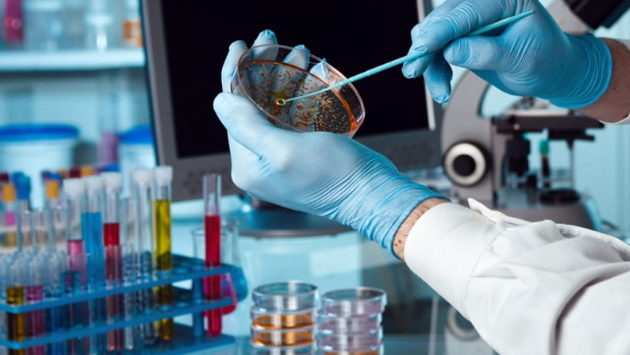
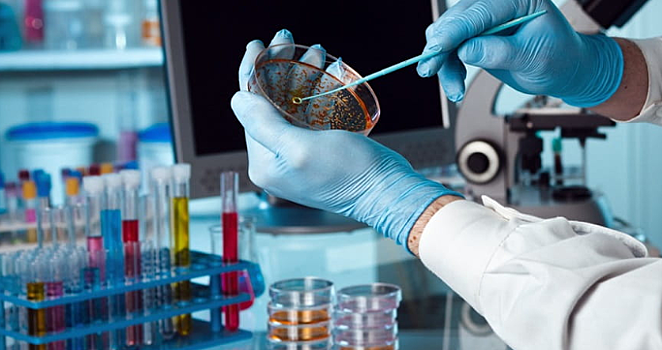
В три больницы в Санкт-Петербурге занесли коронавирус. Они закрыты

В три больницы в Санкт-Петербурге занесли коронавирус. Они закрыты
Они закрыты Персонал и все пациенты будут обследованы на COVID-19 ГБУЗ «Городская больница святого Георгия» ГБУЗ «Александровская больница» ГБУЗ «Введенская больница» В больнице Святого Георгия врачи теперь живут на постоянке, как и пациенты. Всем проводят тесты на корону. У медиков они отрицательные, наблюдение продолжается. По постановлению главного санитарного врача, во все отделения больниц (не только этих) новых пациентов пока не берут. Выписка и перевод из “коронавирусной тройки” запрещены, кроме случаев угрозы жизни и здоровью. Врачам и сёстрам переводиться в другие отделения тоже нельзя.